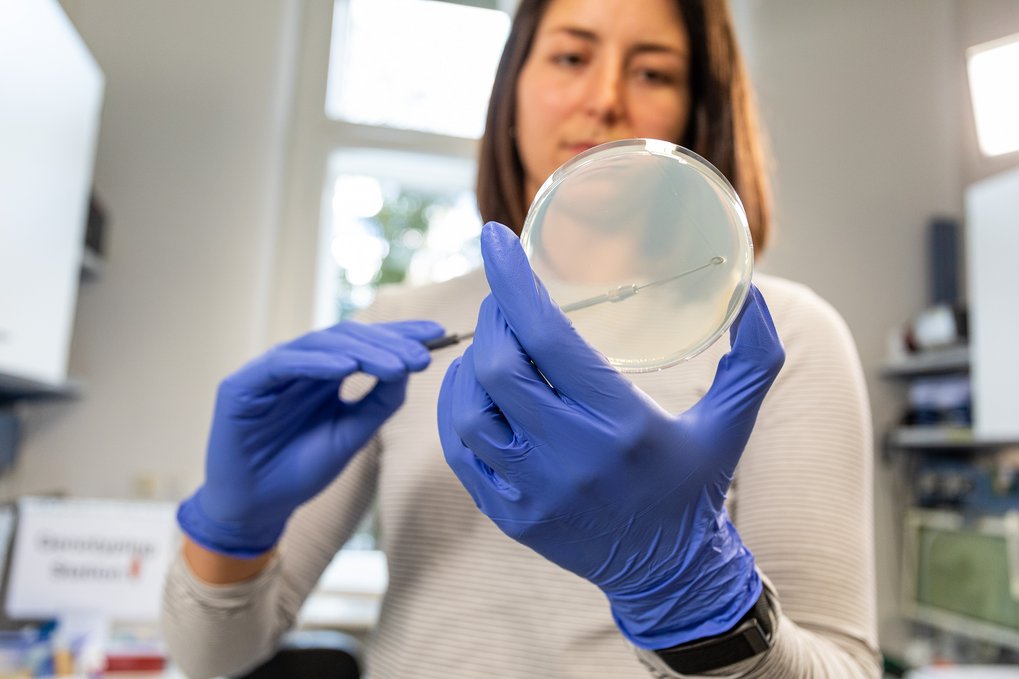
In a laboratory, a female scientist with blue-gloved hands handles a petri dish with a metal inoculating loop, indicating a microbiological experiment.

Clinician Scientist Program. - Next Application Period from September 1st to December 1st 2026
An initiative of the Max Planck School of Cognition
The Max Planck School of Cognition invites applications from top candidates with a background in Clinical Medicine that are interested in pursuing an academic career in fields such as Psychiatry and Neurology to join the newly established Clinician Scientist Program (CSP).
The CSP is comprised of one orientation year followed by three years of doctoral research. In the first year, successful candidates will attend online courses and do clinical work/laboratory rotations with associated fellows of the School of Cognition. From the second to the fourth year, candidates will do their research work and can take one year to focus on their residency training. Flexibility in arranging the residency training time will be granted.
The CSP will initiate on 1st of September, every year.
Selected candidates will receive a competitive monthly income.
Entry requirements:
• Successfully completed medical studies ('Staatsexamen', M.D., or equivalent)
• CV and motivation letter (please refer to 3 potential supervisors from the School’s faculty in letter)
• At minimum two references (includig applicant name in header via direct email to us by referees)
• Interest in pursuing of clinical work while at the Clinician Scientist Program
• English and German language skills at B2 level and willingness to prepare for language examination 'C1 Medizin' at the end of the program
The next application cycle started on September 1st until December 1st 2026 via our application portal for intake fall 2027.
© Photos: Axel Griesch